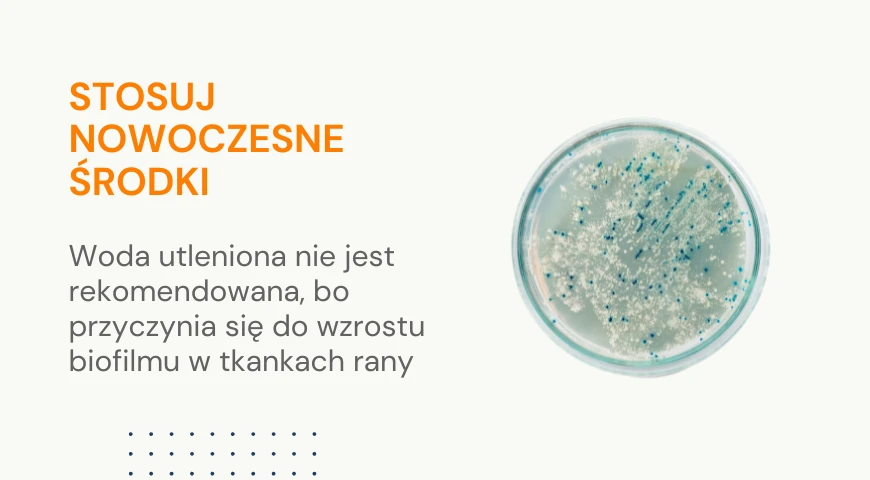
Stosuj nowoczesne środki

Preparaty do odkażania ran - zobacz też czym dezynfekować rany w poradniku poniżej
W tej kategorii znajdziesz produkty niezbędne do oczyszczania i leczenia ran przewlekłych, zakażonych oraz trudno gojących się. Nasz asortyment podzieliliśmy na roztwory i żele do odkażania, specjalistyczne opatrunki piankowe, alginatowe i hydrowłókniste, często wzbogacone o srebro lub substancje przeciwbakteryjne, które wspierają gojenie i zapobiegają infekcjom. Preparaty te są stosowane w leczeniu ran z wysiękiem, owrzodzeń, odleżyn i ran chirurgicznych – pomagają utrzymać odpowiednie środowisko rany oraz przyspieszają regenerację tkanek.
Polecamy też debridementy (tak zwane pady lub "gąbki") do oczyszczania dna rany.

Debrisoft Pad 10 x 10 cm opatrunek do opracowania ran ( 1 szt.) - L&R
Umożliwia usunięcie zanieczyszczeń i wysięku z rany praktycznie bezboleśnie. Oczyszczanie ran powierzchownych, przewlekłych, ostrych.

Epicyn 45g
Silikonowy hydrożel oparty na technologii Microcyn®, do skutecznego leczenia i redukcji blizn - tych świeżych, jak i wieloletnich. Bezwonny, przezroczysty, w 100% bezpieczny dla każdego rodzaju skóry, w tym dla niemowląt i dzieci.

Farmactive Silver Spray 125 ml (1 szt.)
Spray o działaniu antybakteryjnym do ogólnej pielęgnacji ran

Granugel - opatrunek hydrokoloidowy 15 G, żel tuba - ConvaTec
To specjalistyczny żel wspomagający procesy gojenia ran głębokich z martwicą suchą i rozpływową.

Intrasite Gel - hydrożel do oczyszczania ran
preparat w żelu stosowany na rozmaite rany płytkie i głębokie, które wymagają oczyszczania łożyska i nawilżenia.

LavaSurge 1 L.
Jałowy, gotowy do użycia roztwór do zapobiegania zakażeniom i płukania chirurgicznego.

Octenident 250 ml
Zawierający octenidynę, bezalkoholowy płyn do płukania, dekontaminacji oraz nawilżania jamy ustnej i gardła

Octenilin Płyn na rany 350 ml
Płyn do bezbolesnego przemywania ran. Ułatwia bezurazowe zdejmowanie opatrunków.

Octenilin żel 250 ml
Skuteczny żel do leczenia i oczyszczania ran. Zalecany również do leczenia ran przewlekłych.

Octenilin Żel na rany 20 ml - Na otarcia i odleżyny
Hydrożel z oktenidyną. Nawilża i oczyszcza rany, przyspiesza gojenie.

Octenisept krem regenerujący, 50 ml
Regeneruje i pielęgnuje skórę. Zmniejsza zaczerwienienia, łagodzi podrażnienia, działa przeciwzapalnie.

Octenisept żel 20 ml
Do stosowania na rany powierzchowne ostre, otarcia, skaleczenia, oparzenia i rany trudno gojące się

Pediacyn 45g
Silikonowy hydrożel do walki z objawami Atopowego Zapalenia Skóry (AZS) i wypryskami. Dzięki technologii Microcyn® błyskawicznie przerywa cykl swędzenia i drapania, przynosząc ulgę zarówno dorosłym, jak i dzieciom.

Prontosan żel X 250 ml.
Gęsty żel do ran ostrych, przewlekłych i oparzeniowych.

Purilon Gel - opatrunek hydrożelowy 15 g. (1 szt.)
Stosuje się go podczas leczenia ran wymagających delikatnego i skutecznego oczyszczania z tkanek martwiczych.

Zestaw do płukania oka ZPO-1
Zestaw przeznaczony do płukania oka wodą oraz roztworami wodnymi soli fizjologicznej i leków ocznych.

Adhesive Remover 50 ml do usuwania kleju - Braun
Środek do usuwania kleju w formie sprayu. Bezboleśnie usuwa środki klejące.

Debrisoft Lolly (5 szt.)
Opatrunek do opracowywania ran głębokich.
Jak oczyszczać ranę w domu? Praktyczny poradnik dla opiekuna
Omawiamy czym dezynfekować rany, jakie preparaty wybrać i jak prawidłowo odkazić ranę w warunkach domowych. Dzięki praktycznym wskazówkom będziesz wiedzieć, jak zadbać o bezpieczeństwo swoje lub bliskiej osoby.
Oczyszczanie rany to pierwszy i najważniejszy krok w jej leczeniu. Bez tego nawet najlepszy opatrunek nie zadziała w pełni skutecznie. Dobrze oczyszczona rana to mniejsze ryzyko infekcji, szybsze gojenie i większy komfort pacjenta.

Krok 1: Dobierz odpowiedni środek do oczyszczania
❗ Nie używaj do ran zwykłych środków do dezynfekcji skóry (takich jak środki alkoholowe, spirytus, woda utleniona* czy środki do mycia rąk) – mogą uszkadzać zdrowe tkanki i spowalniać gojenie.
❗*Dlaczego nie używa się już wody utlenionej? Badania dowodzą, że woda utleniona pomimo, że dekontaminuje ranę zostawia na jej powierzchni warstwę sprzyjającą narastaniu biofilmu bakteryjnego.
Zamiast tego wybierz specjalistyczne płyny do ran, dostępne w tej kategorii:
- Microdacyn – łagodny, bezpieczny i bardzo skuteczny przy ranach przewlekłych, z wysiękiem, infekcją.
- Prontosan – znany lawaseptyk do oczyszczania ran i usuwania biofilmu.
- Octenilin – delikatny preparat do irygacji ran, polecany szczególnie przy ranach wrażliwych i długotrwałych.
- LavaSurge – jałowy płyn do chirurgicznego płukania ran.
Wszystkie te preparaty pomagają usunąć martwicę, włóknik, bakterie i resztki wysięku, nie uszkadzając zdrowych tkanek i skóry wokół rany która potrzebna jest do gojenia.
Krok 2: Mechaniczne oczyszczanie – skutecznie i bez bólu
Jeśli rana wymaga dokładniejszego oczyszczenia (np. z martwicy czy biofilmu), sięgnij po specjalne kompresy mikrowłókniste, np.:
- Prontosan Debridement Pad – nasącz pad roztworem Prontosan i delikatnie przetrzyj ranę okrężnymi ruchami,
- Schülke Wound Pad – to gotowy zestaw do opracowywania ran przewlekłych.
Dzięki mikrowłóknom te kompresy działają jak delikatna „szczoteczka” – skutecznie zbierają martwe tkanki, łuszczący się naskórek i wysięk bez naruszania zdrowej skóry. Jest to produkt specjalistyczny, ale pomimo wysokiej ceny warto używać go szczególnie w trudnych, zanieczyszczonych ranach.
Krok 3: Kiedy i jak często oczyszczać ranę?
➡️ Zawsze przed założeniem świeżego opatrunku – nawet jeśli rana wygląda czysto.
➡️ Codziennie lub zgodnie z zaleceniem lekarza lub pielęgniarki – szczególnie jeśli rana jest sącząca się, głęboka lub z objawami infekcji.
Jak to zrobić krok po kroku:
- Przygotuj czysty zestaw – rękawiczki, płyn do ran, kompres do przemywania.
- Spryskaj lub przemyj ranę odpowiednim płynem (np. Microdacyn, Prontosan).
- Jeśli trzeba, użyj Prontosan Debridement Pad i delikatnie przetrzyj ranę aż będzie jednolicie różowa.
- Odczekaj chwilę, aż rana obeschnie lub delikatnie ją osusz. Pamiętaj, że każdy środek dezynfekujący działa w czasie (ok 30 sekund).
- Nałóż odpowiedni opatrunek (dobrany do typu rany).
Dlaczego odkażanie ran jest tak ważne?
Każda rana, nawet powierzchowna jak otarcia, to przerwanie ciągłości skóry i tkanek. Niezależnie od tego, czy mamy do czynienia z drobnymi ranami czy większym urazem, otwiera się droga dla bakterii, które mogą doprowadzić do rozwoju zakażenia i stanu zapalnego.
Zakażenie nie tylko spowalnia gojenie ran, ale może też wywołać poważniejsze powikłania ogólnoustrojowe.
Dlatego ranę należy zawsze jak najszybciej oczyścić i zdezynfekować, aby proces gojenia się rany przebiegał prawidłowo i bez bólu. Oczyszczanie wspiera też skuteczność leczenia i działanie opatrunków.
Jakie są etapy prawidłowego oczyszczania i dezynfekcji ran?
Podstawą jest dokładne przemycie — najlepiej roztworem soli fizjologicznej lub specjalistycznymi płynami do odkażania i dezynfekcji, które nie podrażniają i nie uszkadzają tkanki - zarówno skóry wokół rany, ziarniny, ani łożyska rany - jest to cała esencja doboru właściwych środków antyseptycznych.
Dopiero po dokładnym oczyszczeniu rany preparatem można zastosować środki odkażające. Ważne, aby unikać środków na bazie alkoholu etylowego i wody (takich jak roztwór kwasu salicylowego w alkoholu), ponieważ mogą uszkadzać zdrową tkankę i powodować bólu.
Zdecydowanie nie używaj środków do dezynfekcji rąk i skóry - nie nadają się one do dezynfekcji ran.
Z kolei preparaty na bazie oktenidyny, poliheksanidyny biguanidu (PHMB) lub srebra aktywnego (w opatrunkach) działają skutecznie, a jednocześnie są łagodne.
Pamiętaj, że inne środki wykorzystasz do dezynfekcji skóry przed zabiegami, a inne do irygacji i pielęgnacji rany.
Dbaj o aseptykę - wyposaż się w rękawiczki medyczne. zawsze należy dokonywać w sterylnych warunkach. A w razie wątpliwości podczas zabiegu, czy trudności wybrania odpowiedniego środka należy skonsultować się z lekarzem.

Czym odkazić ranę w domu? — najskuteczniejsze preparaty do odkażania (antyseptyki)
W domowej apteczce warto mieć skuteczne preparaty do dezynfekcji ran, które nie uszkadzają zdrowej tkanki i wspierają gojenie się ran.
Najlepiej sprawdzają się nowoczesne środki do odkażania i dezynfekcji, takie jak Microdacyn (związki ponadtlenkowe) czy Prontosan (PHMB) oraz roztwory i żele na bazie oktenidyny np. Octenilin.
Takie preparaty są bezpieczne nawet w przypadkach zainfekowanie rany i mogą być stosowane do odkażania ran pooperacyjnych, otarć czy głębszych zranień, a także trudnych ran przewlekłych.
Niektóre środki, jak opatrunki z dodatkiem srebra aktywnego lub parafiny (Bactigras), dodatkowo działają przeciwbakteryjnie i ograniczają rozwój zakażenia.
Skuteczne środki antyseptyczne - nasza lista najlepszych
W codziennej opiece nad ranami najważniejsze są skuteczność, bezpieczeństwo i łatwość stosowania. Oto trzy sprawdzone preparaty, które szczególnie polecamy naszym pacjentom i opiekunom. Każdy z nich ma swoje unikalne zalety — warto wybrać ten najlepiej dopasowany do potrzeb.
Microdacyn Wound Care 250 ml spray
Microdacyn to innowacyjny roztwór do odkażania ran, który działa na szerokie spektrum bakterii, grzybów i wirusów. Jest wyjątkowo łagodny — nie uszkadza zdrowej tkanki, nie powoduje bólu i można go stosować nawet na błony śluzowe oraz w okolicy jamy ustnej. Świetnie sprawdza się przy otarciach, ranach przewlekłych, ranach pooperacyjnych i oparzeniach.
Przewaga: Możliwość stosowania na bardzo delikatne obszary (także błony śluzowe) oraz brak bólu podczas aplikacji. To idealny wybór dla pacjentów wrażliwych i dzieci.
Prontosan 350 ml
Prontosan to płyn do irygacji ran przewlekłych, oparty na poliheksanidzie i betainie (PHMB). Skutecznie oczyszcza ranę z biofilmu (zanieczyszczonej warstwy bakterii i martwych komórek), co pozwala na lepsze gojenie się ran i ogranicza rozwój zakażenia. Może być stosowany do ran przewlekłych, owrzodzeń, odleżyn czy ran pooperacyjnych.
Doskonała zdolność rozpuszczania i usuwania biofilmu, co ułatwia przygotowanie rany do dalszego leczenia i założenia opatrunku. Bardzo wysoka biokompatybilność (praktycznie nieszkodliwy dla błon śluzowych, podobnie jak Microdacyn)
Octenilin płyn 350 ml
Octenilin to nowoczesny roztwór do płukania i nawilżania ran, oparty na oktenidynie. Działa szybko, ma właściwości antyseptyczne, a przy tym jest bardzo dobrze tolerowany przez tkanki (lepiej od Octeniseptu w ranach głebokich). Dzięki swoim właściwościom można go stosować do ran ostrych, przewlekłych, oparzeń, a także przy pielęgnacji ran pooperacyjnych.
Cechuje go silne i szybkie działanie antyseptyczne przy jednoczesnej delikatności — nie uszkadza zdrowych komórek i wspiera proces gojenia się ran.
Co zaleca konsensus Krammera w kontekście antyseptyki i irygacji ran?
Rekomendowane są nowoczesne preparaty do odkażania ran, np. na bazie oktenidyny (jak Octenilin), poliheksanidu (np. Prontosan) lub preparaty z neutralnym pH (np. Microdacyn). Są one skuteczne, działają szeroko przeciwbakteryjnie i grzybobójczo, a jednocześnie są łagodne dla tkanki i nie wywołują bólu.

Czy woda utleniona i spirytus salicylowy to dobry wybór? (i dlaczego nie)
Woda utleniona i spirytus salicylowy na szczęście są coraz mniej obecne w domowych apteczkach. Wiemy dziś, że mogą bardziej zaszkodzić niż pomóc.
Woda utleniona ma działanie pieniące i mechanicznie oczyszcza ranę, ale jednocześnie może uszkodzić zdrową tkankę, co spowalnia proces gojenia. Ponadto na wytworzonej strukturze piany łatwo kolonizują się bakterie.
Z kolei spirytus salicylowy (a właściwie roztwór kwasu salicylowego w alkoholu etylowym) ma bardzo silne działanie drażniące, a zastosowany na otwartą ranę powoduje ból i może prowadzić do pogorszenia stanu rany. Tym samym osiąga skuteczny efekt dezynfekcji w ranie, ale również uszkadza regenerowane komórki. Zamiast tego, warto sięgnąć po nowoczesne preparaty do odkażania ran, które opisaliśmy wyżej.
Jak dobrać środek do odkażania ran w zależności od rodzaju rany?
Dobór środka powinien zależeć przede wszystkim od stanu rany oraz jej głębokości.
W przypadku powierzchownych ran, jak otarcia czy drobne skaleczenia, wystarczy delikatny płyn do dezynfekcji, który nie wywołuje bólu i nie podrażnia skóry.
Głębsze, trudniej gojące się rany wymagają preparatów w postaci żelu lub sprayu
Nowoczesne środki działają szeroko i chronią przed powikłaniami. Żele też są zaplombowane w sterylnych opakowaniach, co minimalizuje ryzyko kontaminacji żelu.
Pamiętaj: Niezależnie od rodzaju rany, zawsze najpierw ranę należy oczyścić antyseptykiem, a dopiero zastosować opatrunek. Dzięki temu minimalizujemy ryzyko, że doszło do rozwoju zakażenia i zwiększamy efektywność opatrunku.
Co wybrać: płyny, spray czy roztwory do odkażania ran?
Każda forma preparatu ma swoje zalety.
Płyny do dezynfekcji (roztwory)świetnie sprawdzają się do obfitego przemywania i dokładnego oczyszczenia większych ran. Podczas irygacji zużywa się dużo płynu.
Spray to wygodna opcja przy powierzchownych ranach lub w sytuacjach, gdy ważna jest szybkość i komfort aplikacji — szczególnie u dzieci, czy seniorów.
Żele są natomiast najczęściej stosowane przy głębokich, przewlekłych ranach, wymagających systematycznej pielęgnacji.
Warto pamiętać, że wszystkie oferowane przez nas środki do odkażania ran są uniwersalne i mogą być używane zarówno w formie płynu, jak i sprayu. Dobór metody zawsze warto dostosować do rodzaju urazu, stanu rany i możliwości opiekuna — a w razie wątpliwości skorzystać z porady lekarza lub doświadczonego personelu medycznego.

Czy domowe sposoby na odkażanie ran są skuteczne?
Domowe sposoby, takie jak woda utleniona czy spirytus, mogą wydawać się wygodne i „sprawdzone”, ale w rzeczywistości często bardziej szkodzą niż pomagają. Mogą uszkodzić zdrową tkankę, co wydłuża proces gojenia i zwiększa ryzyko powstania stanu zapalnego.
Według konsensusu Krammera, który od lat stanowi ważny punkt odniesienia w leczeniu ran, istnieją metody dezynfekcji, które nie są już zalecane ze względu na ich szkodliwe działanie na tkanki i możliwość opóźniania procesu gojenia się ran.
Stosowanie alkoholu (spirytusu)
Alkohol (np. spirytus salicylowy, roztwór kwasu salicylowego w alkoholu etylowym) silnie drażni tkanki, uszkadza zdrowe komórki, powoduje ból i może prowadzić do pogorszenia stanu rany. Wbrew powszechnemu przekonaniu, jego działanie odkażające nie rekompensuje szkód, jakie wyrządza.
Woda utleniona
Choć przez lata była stosowana jako „pierwsza pomoc”, obecnie wiadomo, że jej pienienie uszkadza zdrową tkankę i opóźnia proces gojenia. Może również doprowadzić do stanu zapalnego lub powstania martwicy brzegów rany.
Stosowanie środków dezynfekujących nieprzeznaczonych do ran może podrażnić ranę i wywołać opisywane wyżej efekty.
Jak dezynfekować rany pooperacyjne i oparzenia?
Rany pooperacyjne oraz oparzenia wymagają szczególnej ostrożności i delikatności. Ranę należy najpierw delikatnie oczyścić, np. przy użyciu roztworu soli fizjologicznej, aby usunąć zanieczyszczenia i martwe fragmenty tkanki. Dopiero potem stosujemy środek antyseptyczny — najlepiej preparat na bazie oktenidyny, który działa skutecznie, ale nie podrażnia. W przypadku oparzeń ważne jest też zastosowanie opatrunku chłodzącego lub specjalistycznych opatrunków przeciwbakteryjnych (np. z dodatkiem srebra), które chronią przed zakażeniem i wspierają regenerację. Jeśli zauważysz niepokojące objawy — np. zwiększony ból, zaczerwienienie czy sączenie — zawsze warto skonsultować się z lekarzem.

Jakie opatrunki stosować po dezynfekcji ran?
Dobór opatrunku zależy od rodzaju i głębokości rany oraz ilości wysięku.
Po dezynfekcji rany wskazanymi wyżej preparatami o wysokiej biokompatybilności badania wykazują mało lub brak skutków ubocznych i reakcji zapalnych. Jest to kolejny ważny argument istotny w całym procesie opieki nad raną.
Do ran z dużym wysiękiem polecamy opatrunki chłonne lub piankowe, np. Aquacel Foam. Przy ranach z ryzykiem infekcji sprawdzą się opatrunki ze srebrem (np. VLIWAKTIV Ag), które dodatkowo działają przeciwbakteryjnie. Ważne, aby opatrunek był dobrze dopasowany — nie powinien uciskać, ale równocześnie musi chronić przed bakteriami i uszkodzeniami mechanicznymi.
Na co zwrócić uwagę, aby przyspieszyć proces gojenia?
Podstawą szybkiego gojenia jest regularna kontrola stanu rany i jej odpowiednia pielęgnacja. Ranę należy oczyścić i zdezynfekować zgodnie z zaleceniami, a opatrunek wymieniać tak często, jak to konieczne (zgodnie z opisem opatrunku, zaleceniami lekarza - a mowiąc szerzej, wieloma innymi parametrami).
Należy unikać preparatów, które mogą uszkodzić tkanki (np. alkohol etylowy) i postawić na środki łagodne, ale skuteczne.
Kluczowa jest też obserwacja objawów — jeśli rana nagle zaczyna boleć, pojawia się zaczerwienienie lub nieprzyjemny zapach, może to oznaczać rozwój zakażenia. Wtedy należy natychmiast skonsultować się z lekarzem. Odpowiednie środki antyseptyczne i właściwe opatrunki to najlepszy sposób na wspieranie naturalnego procesu gojenia i uniknięcie powikłań.
Ważna informacja odnośnie opatrunków ze srebrem (Ag)
Pamiętaj że opatrunki te mogą być stosowane do dwóch tygodni, po tym czasie skuteczności antybakteryjna srebra mocno się zmniejsza i należy je zmienić środek przeciwdrobnoustrojowy - na przykład na opatrunki z PHMB.
W określonych przypadkach możesz użyć opatrunek parafinowy Bactigras - zapoznaj się dokładnie z jego zasadami użycia, bo nie może być stosowany na wszystkie rany. To opatrunek siateczkowy nasączony parafiną z działaniem antybakteryjnym. Można go nakładać pod kompresem chłonnym bezpośrednio na ranę aby ograniczyć ryzyko infekcji.
Protokół leczenia ran konsensusu Kramera rekomenduje stosowanie dwóch antyseptyków na zmianę
Dlatego, do przedłużającego leczenia rekomendujemy stosować przynajmniej dwa środki dezynfekujące do ran.
Podobnie zwykle sytuacja wygląda z środkami przeciwbólowymi.
źródło:






